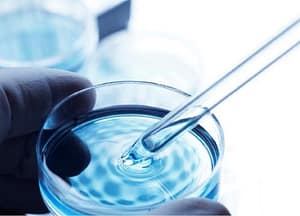

Hacia una vacuna argentina contra la giardiasis
Una vacuna oral contra el parásito Giardia Iamblia, causante de una de las diarreas más comunes en países en desarrollo, ha sido desarrollada por científicos del CONICET y de la Universidad Católica de Córdoba.
Una vacuna oral contra el parásito Giardia Iamblia, causante de una de las diarreas más comunes en países en desarrollo, ha sido desarrollada por científicos del CONICET y de la Universidad Católica de Córdoba. La vacuna ya ha sido probada en forma exitosa en animales domésticos, de granja y de laboratorio. La metodología empleada por los investigadores también podría servir para prevenir la malaria y la tripanosomiasis africana.
(23/09/2011 – Agencia CyTA – Instituto Leloir. Por Bruno Geller)-. Mientras que el consumo de fármacos que tienen como principal blanco al sistema nervioso central se encuentra asociado a las clases económicas más pudientes, en los sectores carenciados los medicamentos más utilizados son los antidiarreicos.
Una de las diarreas más frecuentes en países en desarrollo es la denominada giardiasis, la que es generada por el protozoario Giardia lamblia, un organismo unicelular que se aloja en el intestino delgado de las personas afectadas.
Además de ocasionar diarrea, los síntomas más comunes son gases, malestar general y dolores abdominales. En el organismo, el parásito afecta la absorción de nutrientes y en casos crónicos puede provocar un cuadro de desnutrición, especialmente en niños. Se estima que unos 200 millones de seres humanos son infectados anualmente por este parásito.
La giardasis se contrae principalmente por medio del agua o los alimentos que están contaminados por su contacto previo con materia fecal, tanto humana como animal. La incidencia de la enfermedad podría reducirse aumentando el acceso a redes de agua potable de los sectores más expuestos.
Mientras eso no ocurra, el desarrollo de una vacuna eficaz contra la Giardia lamblia es un logro fundamental para la salud mundial. Y ese es precisamente el objetivo que persigue el grupo de trabajo del doctor Hugo Luján, investigador del CONICET y profesor de la Universidad Católica de Córdoba.
En la actualidad la única posibilidad de controlar la giardiasis es utilizando medicamentos cuyos principios activos no son altamente eficaces y que además suelen presentar efectos secundarios. “Asimismo ya se han registrado cepas de Giardia resistentes a dichos medicamentos. Por otra parte es frecuente la reinfección luego del tratamiento debido a que muchos pacientes no generan mecanismos de defensa eficaces para eliminar el parásito”, afirmó a la Agencia CyTA el doctor Luján.
En este contexto, Luján y su equipo desarrollaron una vacuna contra el parásito que fue probada con éxito en gerbos (roedores). Los resultados de este trabajo fueron publicados en Nature Medicine en abril de 2010. A partir de esta fecha, la versión de la vacuna ha sido mejorada. “La vacuna se ha testeado en animales de laboratorio y animales domésticos, como perros y gatos. También en animales de granja (vacas y terneros). Ahora es necesario probar su eficacia en ensayos clínicos en humanos”, destacó Luján.
La vacuna es sumamente novedosa, tanto por su desarrollo como por sus posibilidades de aplicación. “Se trata de la primera vacuna compuesta solamente por proteínas extraídas del parásito que puede administrarse por vía oral y que no requiere cadena de frío para su mantenimiento y transporte, debido a las características particulares de los antígenos que la componen. Esto facilita su aplicación en lugares donde no hay electricidad ni heladeras para mantener medicamentos en frío”, explicó Luján.
Los reservorios del parásito intestinal Giardia lamblia son las personas, los animales de la fauna silvestre, doméstica y el ganado de consumo, indicó a la agencia CyTA el doctor Eduardo Guarnera, médico epidemiólogo del Centro Panamericano de Zoonosis de la Organización Panamericana de la Salud / Organización Mundial de la Salud. Con el ojo puesto en la salud pública, el doctor Guarnera destacó que la vacuna sería una herramienta “de gran relevancia para evitar las infecciones y reinfecciones permanentes”
Primer round: descubrir el truco de Giardia lamblia
Para desarrollar la vacuna contra la Giardia, Luján y sus colegas se propusieron descubrir cómo hace el parásito para evadir al sistema inmune. Los resultados de este trabajo fueron publicados en la revista Nature a fines de 2008.
Normalmente, las células del sistema inmunológico son capaces de distinguir las células propias de agentes externos, tales como virus, bacterias o protozoarios como la Giardia lamblia. Esta capacidad de discriminación entre lo propio y lo ajeno ocurre a nivel molecular, gracias a interacciones que se producen entre proteínas que están en la superficie de las células del sistema inmune y de los cuerpos extraños. A las proteínas de las células invasoras o los virus se las llama antígenos. Estos pueden ser reconocidos por los anticuerpos, que también son proteínas, pero producidas por células del sistema inmune.
El equipo cordobés descubrió que el parásito es capaz de alterar su aspecto a nivel molecular. “El genoma de este parásito contiene 200 genes que codifican antígenos de superficie diferentes”, señaló Luján. Y continuó: “El problema es que cada parásito exhibe un solo antígeno en su cubierta en un momento dado y cuando el sistema inmune comienza a generar anticuerpos para destruirlo, Giardia reemplaza ese antígeno por otro como si se tratase de un cambio de disfraz. De este modo el sistema de defensa del organismo no puede destruir al parásito”. En otros términos, Giardia lamblia deja continuamente en offside a la respuesta inmune.
Segundo round: revelar los doscientos disfraces del parásito
Para que los antígenos se produzcan, es necesario primero que el ADN de sus genes sea ‘transcripto’ en el núcleo, dando lugar a moléculas de ARN mensajero que luego, en el citoplasma de la célula, se ‘traducen’ en proteínas. Este mecanismo básico de la biología molecular es común a todas las células, pero no todas las células producen las mismas
proteínas.
“Una vez que el antígeno ha sido ‘fabricado’, es transferido a la superficie del parásito. Descubrimos que la maquinaria molecular del parásito en realidad lee y crea instrucciones de la mayor parte de los 200 genes para antígenos de superficie, pero sólo una proteína antigé es ‘fabricada’ y llega a formar parte de la cubierta externa de la superficie del parásito.
Las instrucciones restantes quedan encarpetadas”,subrayó el investigador.
Esa observación sugirió que todos los ARN mensajeros –las instrucciones que menciona Luján– de esta familia de antígenos habían sido creados y estaban dentro del parásito, pero algún mecanismo estaba impidiendo que el ARN fuese traducido a proteínas y expresado en la superficie de la célula. “Por medio de experimentos muy complejos hallamos que un mecanismo celular llamado interferencia por ARN (iARN) impedía que el resto de las instrucciones para antígenos se expresaran.
Nuestros resultados relacionan por primera vez el iARN con el mecanismo de silenciamiento de genes en microorganismos patógenos”, afirmó.
A partir de los resultados, el investigador y sus colegas inhibieron componentes de la maquinaria del iARN que regulan la expresión de los genes para antígenos y observaron que los parásitos no exhibieron un solo antígeno de superficie, sino muchos a la vez.
“Mediante esta técnica pudimos hacer visibles todos los antígenos que el parásito es capaz de producir. Una vez purificados esos antígenos, a partir de parásitos modificados genéticamente para expresar todas esas moléculas, se abrieron las puertas para el diseño de una vacuna efectiva que puede ayudar al sistema inmune a identificar cualquiera de esos antígenos y de ese modo habilitarlo para que ataque a los parásitos que intenten hospedarse en el intestino superior”, explicó Luján.

Tercer round: diseño de una tableta con doscientos antígenos de superficie.
El paso inicial para desarrollar la vacuna consistió en introducir parásitos genéticamente modificados –los que expresaban los 200 antígenos– en un grupo de roedores. “Los animales se volvieron inmunes al parásito, dado que su sistema de defensa generó anticuerpos para cada uno de los antígenos”, subrayó Luján.
Y continuó: “A fin de que la vacuna no consistiera en el desarrollo de parásitos genéticamente alterados, desarrollamos otra, compuesta por la suma de proteínas de superficie aisladas del parásito e integradas en una tableta que puede almacenarse a temperatura ambiente, siendo administrada por vía oral, dos necesidades clave para que una vacuna pueda ser aplicada sin dificultad, sobre todo en países pobres. Ahora es necesario probar su eficacia en ensayos clínicos en humanos, bajo estrictas medidas de seguridad y regulaciones éticas”.
De acuerdo con el investigador podría utilizarse una estrategia similar de inhibición de los mecanismos de variación antigénica de otros parásitos patógenos del ser humano, tales como Plasmodium o Trypanosoma brucei, para prevenir la malaria y la tripanosomiasis africana.
Por tal motivo, los resultados de este equipo de investigación argentino han tenido repercusión en la prensa mundial y “despertado el interés de varias empresas biotecnológicas que se dedican a utilizar este tipo de resultados para la solución de importantes problemas de salud pública”, destacó Luján.
Y agregó: “Paralelamente hemos desarrollado un método simple, económico y sensible para la detección del parásito en materia fecal de organismos infectados. El mismo se basa en una tira reactiva que sirve de soporte para un anticuerpo monoclonal para captura de quistes del parásito y otro anticuerpo marcado para su detección. Estos anticuerpos están dirigidos contra proteínas específicas de la pared del quiste de Giardia y no tienen reacción cruzada con ningún otro componente de la materia fecal. La misma tira contiene además
anticuerpos contra otros protozoarios causales de diarrea (Entamoeba histolytica/dispar y contra Cryptosporidium sp.) lo que permite el diagnóstico diferencial de los tres.”

Medicamentos top biológicos
En la actualidad el licenciamiento de la vacuna que desarrolla el grupo del doctor Luján se encuentra en etapa de negociación con empresas multinacionales para su uso en animales transmisores de la giardiasis (animales domésticos y de granja) y para comenzar estudios en humanos.
Respecto de los avances científicos con aplicaciones médicas –como es el caso del trabajo de Luján– el licenciado Alberto Díaz, director del Centro de Biotecnología Industrial – INTI indicó a la Agencia CyTA que la relevancia de este sector no se da sólo en el plano económico, “sino especialmente por su impacto en la salud de todos nosotros; tener grupos de investigación como los del doctor Luján son una necesidad para servir de base al desarrollo tecnológico innovador. Luego se debe seguir desde lo industrial y lo productivo.
” Y agregó que “también resulta esencial para todo proceso innovador el contar con recursos humanos de calidad, tanto desde el punto de vista científico como tecnológico, que tengan la responsabilidad para hacer llegar sus conocimientos a la sociedad y la vocación de transferir sus resultados a la industria.”
Para Díaz, que también se desempeña como asesor en la Subsecretaria de Transferencia de la Universidad Nacional de Quilmes, “un caso especial de la fabricación es el “biomanufacturing”, muy especialmente para la elaboración de medicamentos en base a la biotecnología. Tan especial es que en 2008 cerca del 30 por ciento del ingreso de los cien medicamentos top fue por productos biotecnológicos y se espera, a nivel mundial, que llegue al 50 por ciento en 2014. La fabricación de estas macromoléculas para el uso en la medicina presenta un desafío a los fabricantes y es de esperar que la Argentina apueste fuerte en este campo».
Sobre las negociaciones que el doctor Luján mantiene con empresas extranjeras para la licencia de la vacuna, Díaz opina que “aunque sea difícil, sería preferible que fueran empresas nacionales porque así se vincularía la investigación realizada en el país con el desarrollo, la innovación y la producción. A través de estos ejes se fortalece estratégicamente el área de la producción industrial en salud humana y animal en el país. Es cierto también que se necesita un papel más activo desde el Estado, y atraer al sector privado para que invierta en estos temas de desarrollo. De todos modos, el transferir a una empresa extranjera es algo de mucho éxito y demuestra la calidad del desarrollo y del grupo de investigación para lograr que el conocimiento no quede solo en las revistas especializa

El doctor Hugo Luján,investigador del CONICET y profesor de la Universidad Católica de Córdoba, lidera el desarrollo de una vacuna oral contra la Giardasis, una de las diarreas mas comunes en paises de desarrollo. La Vacuna se ha probado de forma exitosa en animales domésticos, de laboratorio y de Granja. Ahora es necesario probar su eficacia en ensayos clínicos en humanos.






